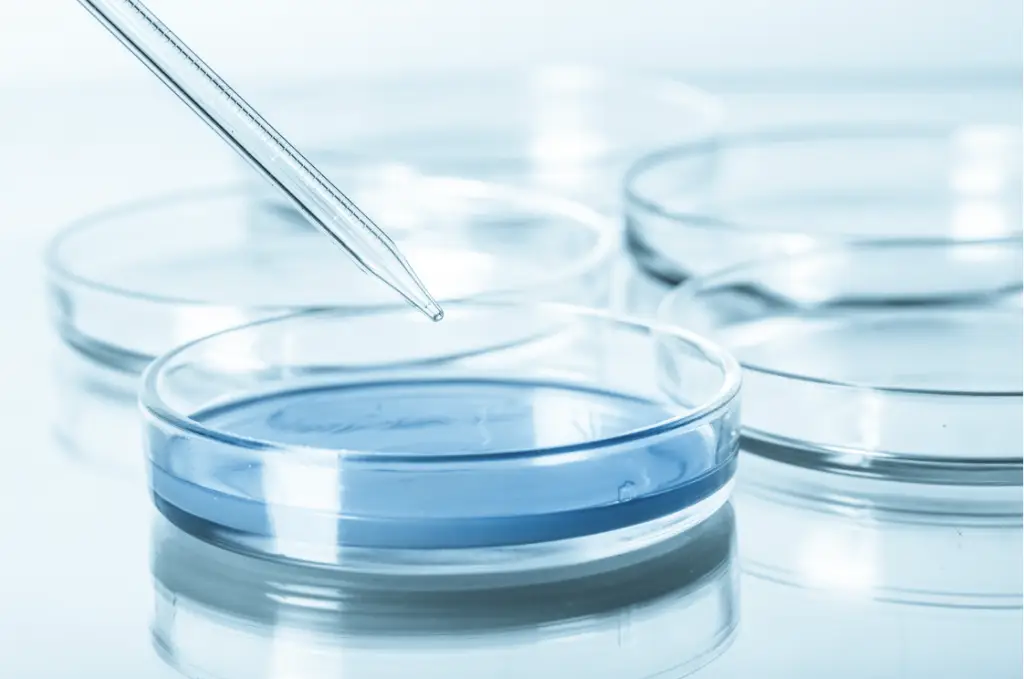
Analyse en laboratoire sur la qualité de l'eau avec une éprouvette

Pourquoi l’analyse d’eau est-elle essentielle ?
Vous pourriez penser que votre eau est pure simplement parce qu’elle est claire et sans odeur. Faites attention les apparences peuvent être trompeuses. Une eau visuellement parfaite peut receler des dangers invisibles. C’est ici que l’importance de faire analyser votre eau devient cruciale, notamment pour ceux qui possèdent un puits privé. Voici les principales raisons pour lesquelles vous devriez envisager cette démarche essentielle :
- Sécurité de consommation : Une eau non testée peut contenir des contaminants nocifs, comme des bactéries dangereuses ou des métaux lourds. Ce qui menacent votre santé et celle de votre famille.
- Responsabilité du propriétaire : En tant que propriétaire, il est de votre devoir de garantir que l’eau que vous et vos proches. Consommez est sécuritaire et conforme aux normes de qualité.
- Surveillance de routine : Les experts conseillent d’analyser l’eau au moins deux fois par an pour s’assurer de sa qualité constante, surtout après des événements climatiques majeurs qui pourraient influencer sa pureté.
- Détection de changements subtils : Une eau qui change de goût, d’odeur, ou d’aspect peut indiquer une contamination. Une analyse rapide permet de déterminer la source du problème et d’y remédier efficacement.
- Prévention coûteuse : Identifier et traiter les problèmes tôt peut vous éviter des dépenses énormes en réparation ou en traitements médicaux ultérieurs.
- Respect des réglementations : Se conformer aux législations locales concernant la qualité de l’eau n’est pas seulement une obligation légale, mais aussi un gage de tranquillité d’esprit.
Les avantages incontestables d’une analyse gratuite chez Culligan Québec
Opter pour une analyse d’eau gratuite avec Culligan Québec n’est pas seulement une mesure préventive. C’est un investissement dans votre bien-être. Voici ce que vous y gagnez :
- Identification proactive des problèmes : L’analyse révèle la présence de contaminants comme le fer, le manganèse, et l’arsenic, souvent responsables de la dégradation de la qualité de l’eau.
- Solutions sur mesure : Selon les résultats, Culligan propose des traitements personnalisés, allant des adoucisseurs d’eau aux systèmes de filtration avancés, pour répondre précisément aux besoins identifiés.
- Amélioration tangible de la qualité de vie : Une eau plus pure signifie une meilleure santé, une peau et des cheveux plus sains, et une durée de vie prolongée pour vos appareils ménagers.
- Flexibilité et commodité : Culligan vous offre le choix entre une analyse à domicile ou en magasin, adaptant ainsi le service à vos besoins spécifiques.
- Accès à l’expertise de Culligan : Profitez des conseils de spécialistes pour naviguer parmi les options de traitement et choisir la meilleure solution pour votre foyer ou votre entreprise.
Comment bénéficier de l’analyse gratuite à Québec ?
C’est simple : contactez Culligan Québec, et un spécialiste se rendra à votre domicile pour prélever des échantillons. Ces derniers seront analysés pour déterminer quels contaminants sont présents et quelle solution est la plus adaptée pour les traiter efficacement.
Les contaminants que Culligan Québec peut détecter
- Minéraux et métaux : Comme le fer, le manganèse, et l’arsenic, qui affectent non seulement la qualité de l’eau mais aussi votre santé.
- Bactéries : Comme les coliformes et E. coli, indicateurs d’une possible contamination fécale.
- Substances diverses : Comme les nitrates/nitrites et les sulfures, qui peuvent altérer le goût et l’odeur de votre eau.
Indicateurs de contamination bactérienne dans l’eau de puits
La qualité de l’eau de puits peut parfois être compromise par des contaminants microbiologiques invisibles. Les principaux indicateurs de cette contamination bactérienne sont les bactéries coliformes et E. coli, des marqueurs fiables de la présence potentielle d’autres pathogènes.
E. coli : Considérée comme le meilleur indicateur de contamination fécale, la présence d’E. coli dans l’eau est un signe clair que l’eau a été contaminée par des matières fécales, humaines ou animales. Cette contamination indique souvent la présence d’autres microorganismes pathogènes, mettant en évidence un risque sérieux pour la santé.
Coliformes totaux : Les coliformes totaux sont généralement trouvés dans les déchets animaux, les eaux usées, le sol et la végétation. Leur présence dans l’eau potable suggère une possible infiltration d’eaux de surface dans le puits, indiquant une contamination bactérienne potentielle.
Ces bactéries sont utilisées comme indicateurs car il est techniquement difficile et coûteux de tester la présence de tous les pathogènes possibles dans l’eau. La détection de ces indicateurs permet d’évaluer la qualité microbiologique de l’eau et de prendre des mesures correctives si nécessaire. Pour les propriétaires de puits, une surveillance régulière de ces indicateurs est cruciale pour assurer une eau potable sûre et saine.
Pourquoi est-il crucial de tester régulièrement votre eau ?
Ignorer la qualité de votre eau peut vous exposer, vous et vos proches, à des risques sanitaires sérieux. Des contaminants non détectés peuvent causer des maladies graves, tandis que des changements non surveillés dans la qualité de l’eau peuvent passer inaperçus jusqu’à ce qu’il soit trop tard pour une intervention simple.
Quels sont les contaminants les plus courants dans l’eau potable au Québec ?
Au Québec, l’eau que nous consommons peut parfois révéler des surprises peu agréables sous forme de contaminants. Que vous utilisiez l’eau du réseau municipal ou un puits privé, connaître les types de contaminants les plus fréquents peut vous aider à mieux protéger votre santé et celle de votre famille.
Ces substances chimiques, présentes dans presque toutes les eaux testées au Québec. Donc notamment dans la densément peuplée vallée du Saint-Laurent, sont de véritables petits cachottiers. Malgré leur discrétion, les PFAS peuvent avoir des impacts significatifs sur la santé à long terme.
Contaminants microbiologiques
Les bactéries coliformes et E. coli sont les indicteurs typiques d’une eau contaminée par des matières fécales. Ceci signalant un danger immédiat pour la santé publique. Ces bactéries sont des signaux d’alarme indiquant que d’autres pathogènes dangereux peuvent être présents.
Minéraux et métaux
Fer, manganèse, arsenic, ainsi que calcium et magnésium (qui contribuent à la dureté de l’eau) sont des invités fréquents dans notre eau. Leur présence peut affecter non seulement le goût de l’eau, mais aussi notre santé, en plus d’endommager nos appareils ménagers.
Autres substances chimiques
Nitrates, nitrites et sulfures, souvent inodores et incolores, peuvent s’accumuler sans être détectés jusqu’à ce que des symptômes de santé apparaissent, rendant leur détection tardive particulièrement risquée.
Contaminants esthétiques
Turbidité, couleur, et odeurs indésirables sont souvent les premiers signes remarqués par les résidents, alertant sur la nécessité d’une analyse plus approfondie.
Risques pour la santé liés à une eau non contrôlée
Ne pas tester régulièrement votre eau, c’est comme naviguer à l’aveugle. Vous pourriez être exposé à des risques sérieux :
- Contamination microbienne : Invisible à l’œil nu, E. coli peut provoquer de sévères gastro-entérites.
- Contamination chimique : Les nitrates et autres produits chimiques peuvent s’accumuler discrètement, causant des dommages à long terme sans signes immédiats.
- Vulnérabilité accrue : Les populations sensibles, comme les enfants, les femmes enceintes, et les personnes âgées, sont particulièrement à risque.
- Maladies d’origine hydrique : Outre les troubles gastro-intestinaux, d’autres pathologies plus graves peuvent être contractées par une eau contaminée.
Comment rester vigilant ?
Tester l’eau de votre puits au moins deux fois par an pour les contaminants microbiologiques. Ainsi qu’une fois par an pour les contaminants chimiques est essentiel. En cas de changements dans l’odeur, le goût ou l’apparence de l’eau. Il est important aussi après des modifications dans l’environnement de votre puits, des tests supplémentaires peuvent être vitaux. Ne laissez pas les contaminants invisibles compromettre votre bien-être. Restez informé, restez en sécurité.
Votre garantie Culligan
Avec Culligan Québec, vous avez la certitude que non seulement votre eau sera testée par des experts. De plus, vous recevrez des solutions adaptées pour maintenir sa pureté à long terme. N’attendez pas que les problèmes surviennent pour votre santé ou vos appareils électroménagers. Soyez proactif avec Culligan et assurez-vous que chaque goutte d’eau dans votre maison ou entreprise est sûre et saine.




